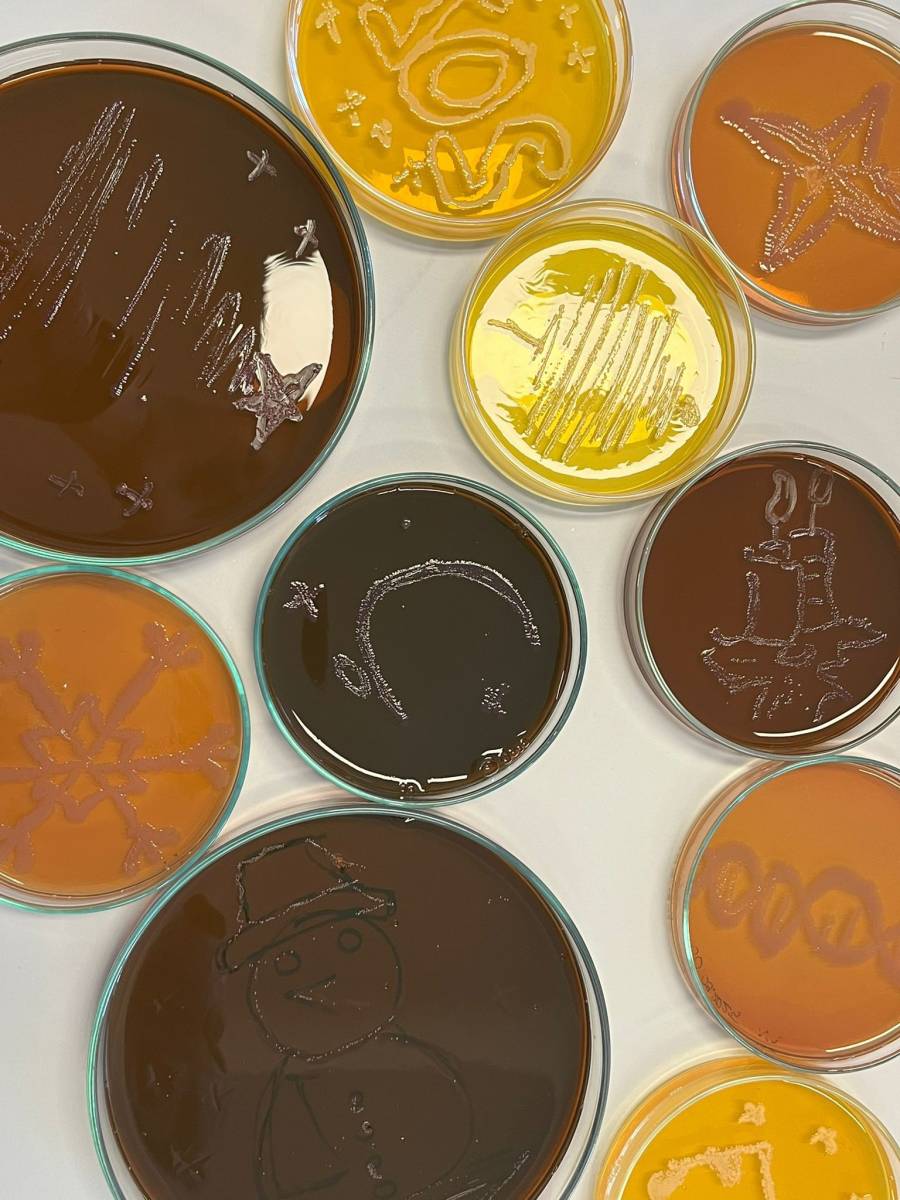
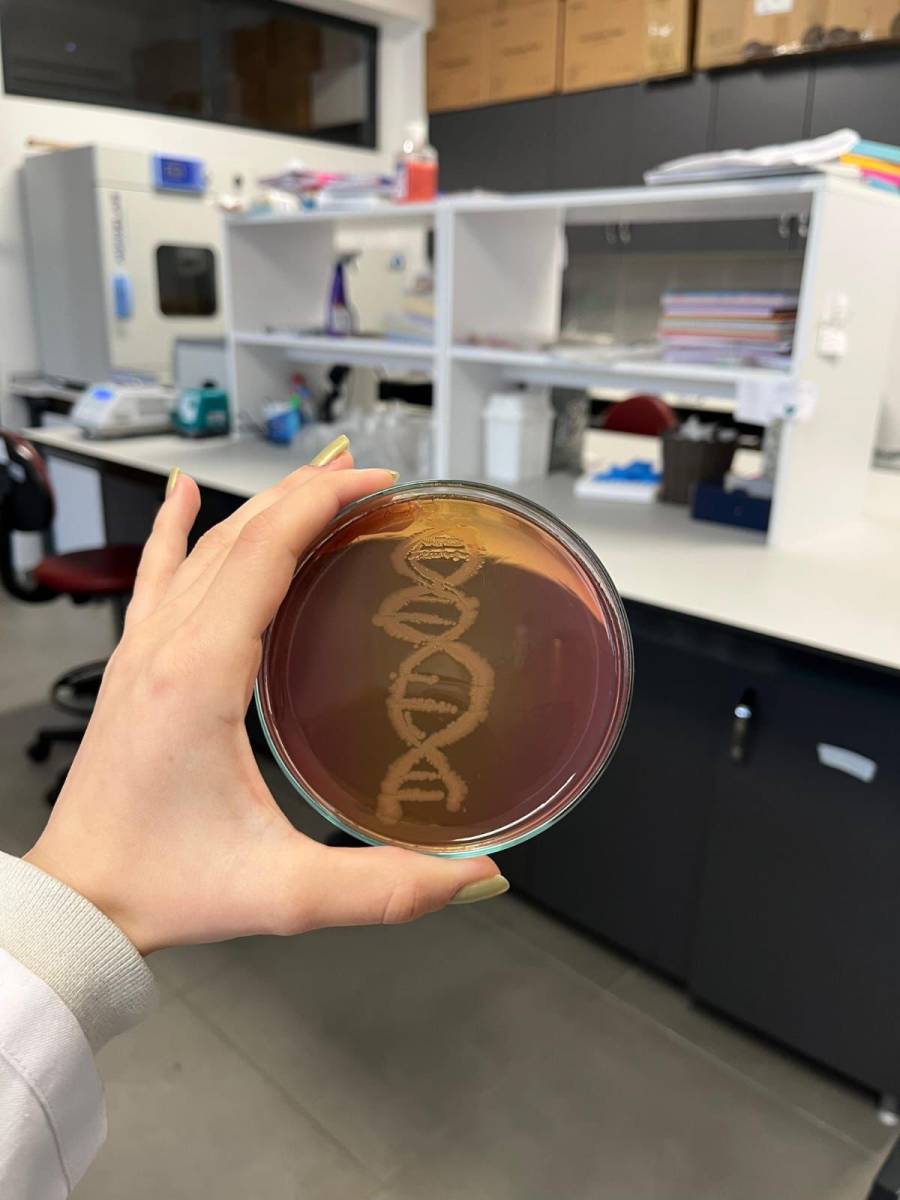

ÖĞRENCİ
Yeni Yıl Temalı Bakteriyografi ve Mikrobiyoloji Sanatı
KTÜ Moleküler Biyoloji ve Genetik Bölümü öğrencileri, 25 Aralık 2025 tarihinde yeni yıl ruhunu laboratuvara taşıyarak yeni yıl temalı bakteriyografi ve mikrobiyoloji sanatı çalışmaları gerçekleştirdi. Etkinlikte öğrenciler, bakteriyel pigmentler ve mikrobiyolojik teknikleri kullanarak yaratıcı görseller oluşturdu.
Bu uygulama, öğrencilerin hem mikrobiyoloji becerilerini pekiştirmelerine hem de bilimsel yaratıcılıklarını geliştirmelerine olanak tanıdı. Keyifli ve öğretici bir atmosferde geçen çalışma, öğrencilere bilim ve sanatı bir araya getiren farklı bir deneyim sundu.

02 Ocak 2026
Bölümümüzde yürütülen akademik ve bilimsel faaliyetler; Rektörümüz Prof. Dr. Hamdullah Çuvalcı'nın katılımıyla gerçekleştirilen toplantıda değerlendirildi.
06 Ocak 2026
KTÜ MBG, KTÜ-GEN iş birliğiyle anlamlı bir sosyal sorumluluk projesine imza attı.
30 Aralık 2025
Bölümümüz, 2025 yılı boyunca yürüttüğü bilimsel çalışmalar sonucunda ulusal ve uluslararası düzeyde önemli akademik çıktılar elde etmiştir.
30 Aralık 2025
Karadeniz Teknik Üniversitesi Moleküler Biyoloji ve Genetik Bölümü tarafından, 2025 yılı sonu değerlendirme toplantısı gerçekleştirildi.
30 Aralık 2025
Doç. Dr. Selcen Çelik Uzuner'in, yeni yaşı öğrencilerinin hazırladığı sürpriz bir organizasyonla ve bölüm başkanı Prof. Dr. Nevzat BATAN'ın katılımıyla kutlandı.
07 Ocak 2026
KTÜ MBG araştırma ve eğitim süreçlerinde verimliliği artırmak amacıyla iyileştirmelere devam ediyor.
27 Aralık 2025
Dr. Öğr. Üyesi Cihan İnan ve ekibinin yürüttüğü araştırma çalışması, yayımlandığı dergide kapak görseli olmaya hak kazanarak önemli bir başarıya imza attı.
30 Aralık 2025
Moleküler Biyoloji ve Genetik Bölümü öğrencileri, tükenmeye yüz tutmuş Türk geleneklerinden biri olan Nardugan Bayramı kapsamında etkinlik düzenledi.
31 Aralık 2025
Proje kapsamında öğrenciler, kampüs içinde yaşayan köpekler için çeşitli noktalara mama ve su kapları bırakarak sokak hayvanlarının beslenme ve suya erişim ihtiyaçlarına katkıda bulundu
31 Aralık 2025
Epigenetik ve Araştırma Grubu, 2025 yılı itibarıyla hizmet alımı yoluyla hücre kültürü analizlerini gerçekleştirmeye başladı.
30 Aralık 2025
Bölüm Başkanımız Prof. Dr. Nevzat Batan başkanlığında Biomics Araştırma Grubu kuruldu
30 Aralık 2025
Bölümümüz Akademisyenleri 2025 TÜBİTAK Yayın Teşvik Ödülü Almaya Hak Kazandı
18 Aralık 2025
Prof. Dr. Ersin Karabacak ile Dr. Ozan Şentürk, hazırladıkları kitap bölümü çalışmaları kapsamında bölümümüz öğretim üyesi Doç. Dr. Murat Erdem Güzel?i ziyaret etti.
05 Aralık 2025
Öğrencilerimiz, mesleki ve kişisel gelişimlerine katkı sunmak amacıyla mesleki tanıtım etkinliği gerçekleştirdi.
02 Ocak 2026